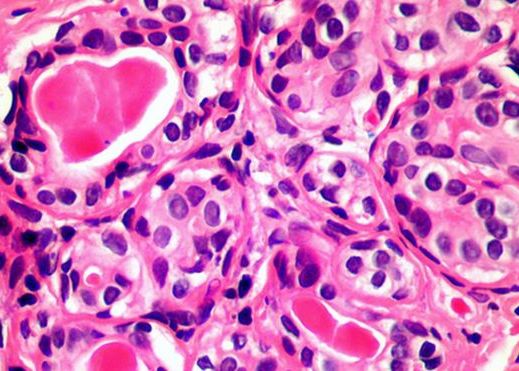

Descoperirea care ar putea ajuta la tratarea tuturor formelor de cancer
Cercetătorii au descoperit o nouă funcție a sistemului imunitar uman care ar putea fi valorificată pentru a trata toate tipurile de cancer.
Echipa de oameni de știință de la Universitatea din Cardiff a identificat, cu ajutorul testelor de laborator, o nouă metodă pentru eliminarea cancerului de prostată, de plămâni, dar și a altor tipuri. Tratamentul nu a fost până acum testat pe pacienți, dar cercetătorii susțin că acesta are un „potential imens”.
Sistemul nostru imunitar este, în același timp, atât protectorul natural al corpului împotriva infecțiilor, cât și un „dușman” al celulelor canceroase, așa că specialiștii au încercat să găsească moduri „neconvenționale” și nedescoperite până acum prin care bariera imunitară umană atacă tumorile maligne. Astfel, au ajuns să analizeze un tip de celulă T care există în sângele oamenilor și care, pe scurt, poate „scana” corpul pentru a identifica amenințări care trebuie eliminate. Iar marea diferență este că aceasta poate acționa eficient în cazul multor tipuri de cancer.
„Există posibilitatea să reușim, în viitor, să tratăm fiecare pacient. Anterior, nimeni nu credea că este posibil așa ceva. Descoperirea crește șansele unui tratament universal pentru cancer, pentru că un singur tip de celulă T este capabil să distrugă multe manifestări distincte ale bolii”, a declarat cercetătorul Andrew Sewell pentru BBC.
Celulele T au pe suprafața lor receptori care le permit să „vadă” la nivel chimic, iar oamenii de știință au descoperit că o astfel de structură, împreună cu receptorii săi, pot descoperi și anihila tipuri variate de celule canceroase, inclusiv cele care își fac loc în plămâni, piele, sânge, colon, sâni, oase, prostată, ovare, rinichi sau cervix. La fel de important este și faptul că, astfel, țesuturile normale nu sunt afectate. Cum se întâmplă exact acest lucru rămâne, însă de explorat.
Până acum se știe că acest tip de celulă T interacționează cu o moleculă numită MR1, care se află pe suprafața oricărei celule din corpul uman, iar aceasta ar putea fi cea care „alertează” modificarea de metabolism și indică locul în care se află celula canceroasă.
Deși în prezent tratamentul pe bază de celule T există deja, evoluțiile în materie de imunoterapie sunt unele dintre cele mai interesante din acest domeniu. Una dintre cele mai cunoscute astăzi este faimosul exemplu CAR-T, un „medicament viu” care este realizat prin construirea artificială a celulelor T ale unui pacient, cu scopul precis de a căuta și a distruge cancerul. Acest tratament poate avea rezultate spectaculoase, dar abordarea trebuie să fie una personalizată și are efect doar în cazul unor anumite manifestări ale acestei boli.
Cum ar funcționa noul tratament în practică? Acesta ar fi realizat pe baza unei mostre de sânge luate de la pacient, din care ar urma să fie extrase celulele T și, ulterior, modificate genetic și reprogramate în așa fel încât să se transforme într-un receptor activ care să detecteze țesuturile canceroase. Aceste noi celule ar urma să fie cultivate în laborator în cantități mari, iar apoi reimplantate în organismul pacientului. Până la această etapă, însă, e nevoie de multe teste, în așa fel încât să fie certificat faptul că ele sunt sigure pentru utilizarea la oameni.